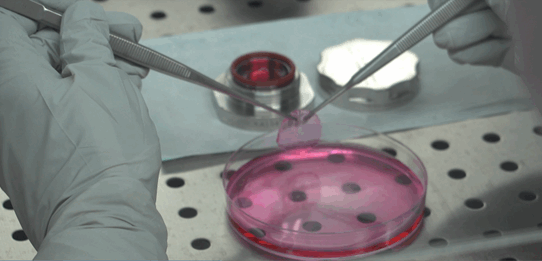
A holostem petri dish

A life-changing treatment to reverse injury-related sight loss is now available to patients at specialist centres across England, thanks to a partnership between Newcastle Hospitals and Italian medicines manufacturer, Holostem.
The specialist advanced therapy, known as Holoclar, uses stem cells to treat sight loss due to physical or chemical burns to the eye.
The treatment is made by taking healthy cells from the patient’s uninjured eye before sending them to Italy where they are used to cultivate a new corneal epithelium – the clear ‘barrier’ that protects the eye.
The product must be transplanted onto the damaged eye within 36 hours of release.
This short shelf life makes timing critical and legislative constraints were making it difficult to import Holoclar for use at the four NHS sites approved to carry out the treatment.
Adam Walker, specialist quality assurance pharmacist at Newcastle Hospitals, explains how his team worked to unlock access for the wider NHS:
“Over a number of months, quality assurance specialists from our pharmacy directorate worked extensively with Holostem, providing advice, guidance and support to overcome the import challenge and develop appropriate regulatory authorisations.
“Our work addressed the previous supply constraints, making the treatment quickly and easily available for NHS use, so specialist centres can now restore the sight of the patients who receive it.
“Using the same authorisations, our team is now in a position to assist other manufacturers to offer innovative products within the NHS.”
Irving Donandon from Holostem said:
“Holoclar is available to patients in a number of other European countries and we wanted NHS patients in the UK to benefit too.
“This new distribution model is a fantastic collaboration between NHS pharmacists and private industry and has been fundamental to overcome the access constraints we experienced.
“With a joint focus on improving patient’s lives, our partnership proves how different sectors can work together to make the best possible treatments available to people.”
The partnership between the Newcastle Hospitals and Holostem was facilitated by the Northern Alliance Advanced Therapies Treatment Centre, which works to support the use of advanced therapies and ensure access for NHS patients.
- A short explainer film about the project is available here Unlocking the availability of sight saving treatment for NHS patients v3 – YouTube)
- Holostem is a biotech based into the Centre for Regenerative Medicine of the University of Modena. It is the first biotech entirely devoted to development, manufacture, registration and distribution of advanced therapies medicinal products based on cultures of stem cells, for cell and gene therapy.
- The Northern Alliance Advanced Therapies Treatment Centre (NA-ATTC) is a consortium of twenty industry, NHS and academic organisations led by Newcastle Hospitals and the Scottish National Blood Transfusion Service. The centre develops systems and infrastructure to support the delivery of cell and gene therapies, with the aim of increasing patient access to advanced therapy medicinal products on a national level.